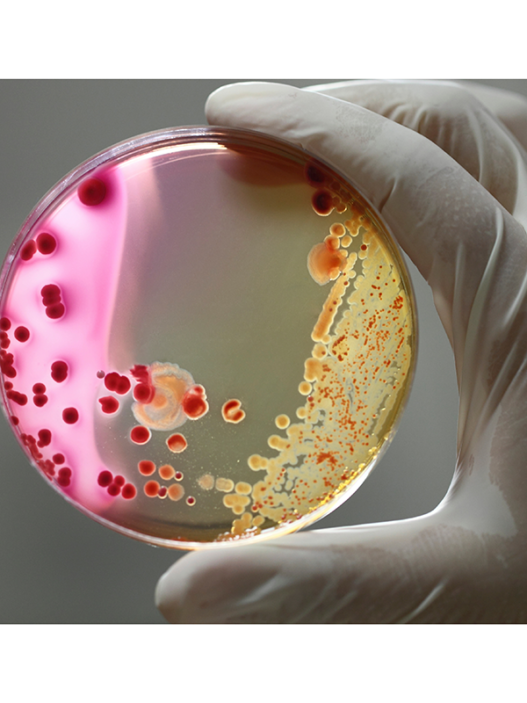

The initiative, titled ‘Code with Pope’, aims to address the significant disparities in education observed worldwide, particularly in the realm of computer programming.
Mironiuk, the founder of the artificial intelligence company Cosmose AI, has a personal testimony of how coding drastically transformed his life. He believes that by introducing children to programming from an early age, they too can experience the life-changing benefits of technological literacy. “It is our vision to bridge the glaring disparities in education across various regions,” he commented in a recent interview with the BBC.
The Pope’s involvement is expected to resonate particularly well in Catholic-majority countries, and Mironiuk is optimistic about the impact it will have. “We believe the Pope’s support will inspire these nations to utilise this free educational opportunity and learn programming,” he said.
The primary objective of the ‘Code with Pope’ initiative is to provide access to a free online coding platform tailored for students aged 11-15, spanning Europe, Africa, and Latin America. After completing 60 hours of dedicated study, participants will gain foundational knowledge in Python.
In this evolving digital era, the importance of programming proficiency parallels that of traditional literacy skills. According to data from the World Economic Forum in 2023, technology-focused roles dominate the list of rapidly growing professions. Yet, an acute global tech skills shortage looms on the horizon, with projections suggesting that up to 85 million job roles could remain vacant by 2030.
This deficiency underscores the urgency of expanding access to quality programming education, especially in low to middle-income nations. It’s noteworthy that many of these countries have significant Catholic populations, a demographic Mironiuk hopes to reach.
Poland, Mironiuk’s home country, is renowned for its strong Catholic identity and burgeoning tech industry. The entrepreneur, aged 33, expressed pride in his Polish roots and the nation’s burgeoning success in the tech sector, with leading firms such as Google Brain, Cosmose AI, and Open AI employing a significant number of Polish professionals. However, Mironiuk recognises that many countries have yet to realise similar successes, prompting his dedication to this global educational endeavour.
The ‘Code with Pope’ programme will be accessible in Spanish, English, Italian, and Polish, targeting children in South America (excluding Brazil), English-speaking African nations, and parts of South East Asia.